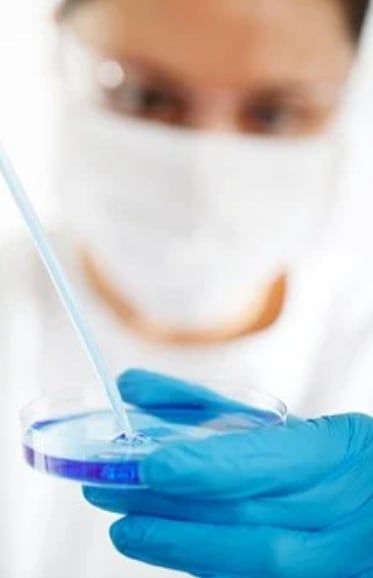

1. 건강검진이란




안녕하세요~ 오늘은 건강검진이란 무엇인지... 그리고 연령별 성별별 건강검진 시기 건강검진 시 유의사항 건강검진 대상자 조회방법 등에 대해 자세히 알아보는 시간 가지도록 하겠습니다.
건강검진은 크게 두 가지로 나뉩니다. 국가건강검진과 직장인 검진입니다. 국가 건강검진은 지역 세대주, 만 20세 이상 세대원, 만 19~64세 의료급여 수급권자가 대상입니다. 홀수연도에는 홀수년 생, 짝수연도에는 짝수년 생이 검진을 받을 수 있습니다.
직장인 검진은 사무직은 2년 주기로, 비사무직은 매년 받는 것이 원칙입니다. 제때 검진받지 못하면 검사 기회를 잃지만, 올해 6월까지는 홀수년생뿐 아니라 지난해 검진을 받지 못한 짝수년 생도 받을 수 있습니다.
1. 일반건강검진
고혈압, 당뇨병, 이상지질혈증 등 질환의 조기발견과 생활습관 개선이 목적
• 대상 : 직장가입자, 세대주인 지역가입자, 만 20세 이상 지역 세대원 및 피부양자(매 2년마다 1회, 다만 직장가입자 중 비사무직은 매년)
※ 의료급여수급권자: 만 19~64세 세대주(만 66세 이상은 의료급여 생애전환기 검진 시행)
• 검사항목 : 공통항목 및 성·연령별 항목
• (공통항목) 진찰 및 상담, 신체계측, 시력·청력검사, 흉부방사선 검사, 혈액검사, 요검사, 구강검진
• (성·연령별 항목) 혈액검사, B형간염항원·항체, 골밀도 검사, 인지기능장애, 정신건강검사, 생활습관 평가, 노인 신체기능 검사, 치면세균막 검사로 검사항목별 대상 연령과 주기가 변경됨
※ 건강검진결과 고혈압, 당뇨병 질환 의심자는 확진검사 실시
2. 암검진
발생률이 높고 조기진단으로 치료할 수 있는 5대 암 대상으로 실시
• 대상 암종 및 연령 : 위암(40세 이상, 2년 주기), 대장암(50세 이상, 1년 주기), 유방암(40세 이상, 2년 주기), 자궁경부암(20세 이상, 2년 주기), 간암(40세 이상 고위험군, 6개월 주기)
※ 국가건강검진의 대장내시경 검사를 받은 자와 대장암 환자로 산정특례 적용자에 대해 대장암 검진 5년간 유예
3. 영유아 건강검진
모든 영유아가 건강하게 성장할 수 있도록 필수적인 검진과 보호자 교육을 실시
· 대상 : 6세 미만(71개월 이하)의 영유아
· 검진항목 : 진찰 및 신체계측, 발달평가 및 상담, 건강교육, 구강검진
4. 건강검진 실시기간
· 당해 연도 12월 31일까지(다만, 확진검사 및 2단계 검사(위암, 대장암)는 다음 연도 1월 31일까지)
※ 영유아검진은 출생 시기(4개월~71개월) 별 7차에 걸쳐 실시
5. 비용부담
· 일반건강검진, 확진검사, 영유아 건강검진 > 본인부담 없음
· 암검진 > 본인부담 10%(국가 암 대상자 및 자궁경부암 · 대장암은 본인부담 없음)
건강검진 절차
• 건강검진 대상자 확인
- 공단에서 검진대상자에게 발송한 검진 확인서로 검진종목 및 항목 확인
• 검진기관 예약 및 방문
- 거주지에 상관없이 지정된 검진기관 어디서나 받을 수 있으며 검진기관에 건강검진표와 신분증 지참하여 검진 실시
• 검진결과 통보
- 검진 받은 검진기관에서 수검자에게 검진 결과 발송
문의 : 국민건강보험공단 고객센터 ☎ 1577-1000
2. 건강검진 연령별 검사항목

건강검진 성별/연령별 검사항목
치면세균막검사(만40세)
B형 간염검사(만 40세, 보균자 및 면역자는 제외)
생활습관 평가(만 40,50,60,70세)
노인 신체기능 검사(만 66,70,80세)
이상지질혈증(총 콜레스테롤, HDL 콜레스테롤, LDL 콜레스테롤, 트리글리세라이드) -> 남자의 경우 만 24세, 28세, 32세...., 여자의 경우만 40세, 44세, 48세... 만 해당
골다공증(만 54,66세 여성)
정신건강검사_우울증(만 20,30,40,50,60,70세)
인지기능장애 검사(만 66세 이상 2년에 1회)
3. 건강검진 대상 / 공통 검사항목




건강검진 대상
일반 건강검진 대상자는 지역 세대주와 만 20세 이상 세대원과 피부양자 그리고 직장가입자와 만 19세~64세 의료급여 수급권자가 대상입니다. 2년마다 1회로 이루어지며 비사무직은 매년 실시합니다.
건강검진 공통 검사항목
진찰, 상담, 허리둘레, 신장, 시력, 청력, 혈압측정, 체중, 체질량지수
AST, ALT, 감마지티피
구강검진
공복혈당
요단백, 신 사구체여과율, 혈색소, 혈청 크레아티닌
흉부방사선 촬영
4. 건강검진 주의사항




건강검진 주의사항
검진 전날 저녁 9시 이후 금식
검진 당일은 입에 물도 대지 않기
최소 8시간 이상 공복 상태 유지하기
검진기간은 매년 1.1 ~ 12.31까지(건강검진의 연장은 없음)
5. 건강검진 대상자 확인방법




국민건강보험
www.nhis.or.kr
▲ 위 링크를 클릭해서 국민건강보험 사이트에 접속합니다.

▲ 그다음 건강검진 대상 조회 메뉴를 클릭합니다.

▲ 그러면 로그인하라고 나올 겁니다. 저는 공인인증서가 있어서 공인인증서 로그인을 했습니다. 여러분들도 로그인을 해주시면 되겠습니다.

▲ 저는 대상자가 아니라고 나오네요~ 만약 올해 건강검진 대상자이시라면 대상자라고 뜰 겁니다~ 참 쉽죠~
이렇게 해서 건강검진 대상자 조회방법에 대해 알아보았습니다. 여러분이 준비할 것은 공인인증서 또는 브라우저 인증서를 준비하는 것입니다.
이렇게 해서 건강검진은 무엇인지 연령별 성별별 검강검진시기 검강검진시 주의사항 그리고 검강검진 대상자 조회방법까지 자세히 알아보았습니다. 검 강검진을 놓치지 말고 제때 받아서 몸에 이상이 있는지 체크하는 게 무엇보다 중요하죠~ 건강을 잃으면 모든 것을 잃는 것이니깐요~ 이번 포스팅은 여기서 마치도록 하겠습니다. 모두 건강하시고 행복한 하루 보내세요~ ^^
♥공감은 고래도 춤추게 합니다~ ^^
'건강나라' 카테고리의 다른 글
| 콜레스테롤 낮추는 방법 / 좋은 음식 운동 (0) | 2021.08.20 |
|---|---|
| 설사 원인 배탈 증상 예방 치료 방법 좋은음식 (0) | 2021.06.27 |
| 눈에 좋은 음식 시력 회복 운동 트레이닝 (0) | 2021.05.18 |
| 만성 콩팥병 원인 증상 신부전증 예방 치료 방법 (0) | 2021.05.09 |
| 골다공증 원인 증상 예방 치료 방법 이란 (0) | 2021.05.05 |
| 빈혈 증상 원인 예방 치료 방법 좋은음식 (0) | 2021.05.04 |
| 고지혈증 증상 원인 예방 치료 방법 이란 (0) | 2021.05.03 |
| 코골이 치료법 / 줄이는 방법 / 수면 무호흡 원인 (0) | 2021.05.01 |





댓글